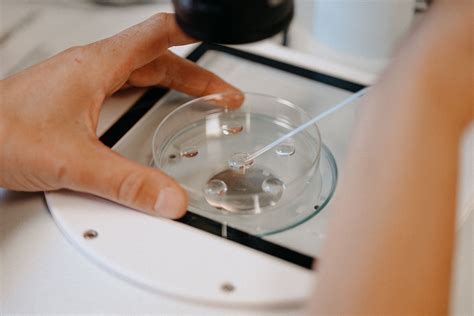
Infographic die het proces van embryo invriezen en ontdooien illustreert

Wanneer na een IVF- of ICSI-behandeling embryo's ontstaan die geschikt zijn voor invriezen, kunnen deze ingevroren embryo's na ontdooiing worden teruggeplaatst in de baarmoeder. Dit proces, bekend als cryopreservatie en terugplaatsing, biedt een waardevolle optie voor koppels die streven naar een zwangerschap.
Embryokwaliteit: De Basis voor Succes
Niet elk embryo is geschikt om in te vriezen; de mogelijkheid hiertoe is afhankelijk van de kwaliteit van het embryo. Verdere informatie over de criteria voor embryokwaliteit is te vinden in de relevante brochures.
Terugplaatsing van een Ontdooid Embryo: Twee Methoden
Er zijn twee hoofdmethoden voor de terugplaatsing van een ontdooid embryo in de baarmoeder: de natuurlijke cyclus en de kunstmatige cyclus.
De Natuurlijke Cyclus
Bij vrouwen met een regelmatige menstruatiecyclus kan een embryo vaak worden teruggeplaatst in hun natuurlijke cyclus. Gedurende deze cyclus is medicatie nodig om de rijping van het baarmoederslijmvlies optimaal af te stemmen op het embryo. Bij een normale cyclus vindt de eerste echocontrole doorgaans plaats op de tiende dag van de cyclus.
Contact en Planning: Voor vragen en planning kunt u telefonisch contact opnemen op maandag tot en met vrijdag tussen 9.00 en 11.30 uur.
De Kunstmatige Cyclus
In gevallen waar terugplaatsing in een natuurlijke cyclus niet haalbaar is, wordt een kunstmatige cyclus nagebootst met behulp van medicatie. Dit is met name relevant voor vrouwen met een zeer onregelmatige of afwezige cyclus.
Verloop van de Behandeling
Uw arts zal de details van de behandeling met u bespreken, inclusief de recepten voor de benodigde medicijnen en de startdatum van de behandeling. De startdatum is doorgaans afhankelijk van het begin van uw volgende menstruatie. Indien nodig, kan medicatie worden voorgeschreven om de menstruatie op te wekken.
Medicatie: Ophalen en Gebruik
De medicijnen kunnen worden opgehaald bij de apotheek in het UMC Utrecht. Het is raadzaam om een actueel medicatieoverzicht van uw eigen apotheek mee te nemen. U kunt er ook voor kiezen om de recepten voor Progynova® en Utrogestan® naar uw eigen apotheek te laten sturen.
Starten met Medicatie
Op de eerste dag van uw menstruatie dient u contact op te nemen met het inplanspreekuur van de polikliniek. U start, zoals met uw arts afgesproken, met het eerste medicijn (Progynova®). Na minimaal tien dagen Progynova® wordt een echo-onderzoek gepland om de opbouw van het baarmoederslijmvlies te beoordelen. Indien uw menstruatie in het weekend begint, start u met het medicijn en belt u op maandag met het inplanspreekuur.

De Terugplaatsing van het Embryo: Een Gedetailleerd Proces
Embryo terugplaatsingen vinden doorgaans 's middags plaats. Het embryo wordt een dag eerder in het laboratorium ontdooid.
Communicatie en Timing
Op de dag van de geplande terugplaatsing ontvangt u tussen 11.00 en 12.00 uur een sms met het exacte tijdstip. Indien het embryo de ontdooiprocedure niet goed heeft doorstaan en terugplaatsing niet mogelijk is, ontvangt u geen sms en wordt u telefonisch op de hoogte gesteld.
Het Procedurele Verloop
De terugplaatsing zelf is niet pijnlijk. U neemt plaats in een gynaecologische stoel. Met behulp van een speculum wordt de baarmoedermond zichtbaar gemaakt. Een verpleegkundige voert een buikecho uit om de procedure te volgen. Een laboratoriummedewerker zuigt het embryo op in een dunne, flexibele katheter. De arts schuift de katheter via de baarmoederhals de baarmoeder in. Soms gaat dit moeiteloos, soms vergt het wat meer tijd. Het embryo wordt vanuit de katheter in de baarmoeder geplaatst. Om zeker te zijn dat het embryo volledig is overgebracht, controleert de laboratoriummedewerker onder de microscoop of de katheter leeg is.
Belangrijke Voorbereiding
Een gevulde blaas kan de terugplaatsing vergemakkelijken. Daarom wordt geadviseerd om twee uur voor de terugplaatsing niet meer naar het toilet te gaan.

Na de Terugplaatsing: Zwangerschapstest en Vervolg
U ontvangt na de terugplaatsing een formulier met de datum voor de zwangerschapstest.
Zwangerschapstest Resultaten
Als de behandeling niet tot een zwangerschap heeft geleid, kan het zijn dat u voor de testdatum al gaat menstrueren. Bij een terugplaatsing in een kunstmatige cyclus blijft de menstruatie waarschijnlijk uit, zelfs bij een negatieve test. Indien u bloedverlies ervaart en twijfelt of dit een menstruatie is, is het belangrijk om alsnog een zwangerschapstest te doen. Bij een negatieve test bent u niet zwanger en wordt u verzocht deze uitslag door te geven aan de verpleegkundige tijdens het verpleegkundig spreekuur.
Nieuwe Behandelingen en Opties
Als u nog ingevroren embryo's over heeft en een nieuwe terugplaatsing wenst, kunt u via het inplanspreekuur informeren naar de beschikbaarheid. U kunt hier ook een herhaalrecept voor hormonen aanvragen indien nodig. Indien u geen ingevroren embryo's meer heeft, kunt u een afspraak maken bij een fertiliteitsarts voor een eventuele nieuwe IVF/ICSI-behandeling.
Specifieke Situaties: Embryo's na Invriezen van Eicellen en PGT
In sommige behandelingen worden eicellen ingevroren in plaats van embryo's. Om hieruit een embryo te verkrijgen voor terugplaatsing, zijn er verschillende behandelschema's beschikbaar, afhankelijk van factoren zoals de regelmaat van de menstruatiecyclus.
PGT (Preïmplantatie Genetische Test): Dit is een methode die wordt gebruikt om de geboorte van kinderen met ernstige erfelijke aandoeningen te voorkomen. Meer informatie over de terugplaatsing van een ontdooid embryo na PGT is beschikbaar.
Informatie over Cryopreservatie en Opslag
Het invriezen van embryo's vindt meestal plaats een dag nadat een 'vers' embryo is teruggeplaatst, en alleen als de embryo's goed zijn doorgedeeld. Embryo's kunnen jarenlang in vloeibare stikstof worden bewaard zonder verlies van vitaliteit, omdat alle biologische processen stilgezet worden.
Bewaartermijn: De bewaartermijn voor ingevroren embryo's is vastgelegd op 5 jaar.
Overlevingskans: Ongeveer 92% van de ingevroren embryo's overleeft de invries- en ontdooiprocedure.
Voorbereiding op een Cryo-Terugplaatsing
De terugplaatsing van een ingevroren embryo kan plaatsvinden in een natuurlijke of kunstmatige cyclus. De arts bespreekt de meest geschikte methode voor uw situatie.
Monitoring van de Cyclus
Voor een terugplaatsing in een natuurlijke cyclus is het essentieel om de timing van de eisprong te kennen. Dit kan worden gedaan met behulp van ovulatietesten die het luteïniserend hormoon (LH) in de urine detecteren. Een positieve test geeft aan dat de eisprong binnen 24-36 uur zal plaatsvinden.
Advies Ovulatietesten: De Clearblue® ovulatietest (Clearblue DIGITAL ovulatietest) wordt aanbevolen. Het is belangrijk om de instructies nauwkeurig te volgen en de testresultaten door te geven.
Gestimuleerde Cyclus met Medicatie
In een gestimuleerde cyclus worden medicijnen gebruikt voor de groei van follikels, zoals Letrozol. De groei van het baarmoederslijmvlies wordt gemonitord via echo-onderzoeken. Medicatie zoals Progynova en Utrogestan wordt voorgeschreven om de groei van het baarmoederslijmvlies te ondersteunen.
Rol van Medicatie
Progynova (Estradiol) stimuleert de groei van het baarmoederslijmvlies. Utrogestan (Progesteron) ondersteunt de innesteling van het embryo. Foliumzuur wordt ook geadviseerd.
Praktische Informatie en Contact
Voor praktische informatie over afspraken en procedures kunt u terecht op het patiëntenportaal Mijn UMC Utrecht. Het IVF-centrum is telefonisch bereikbaar voor specifieke vragen.
Belangrijk: Het IVF-laboratorium in Tilburg belt u alleen als de terugplaatsing niet doorgaat. Voor het exacte tijdstip van terugplaatsing kunt u kijken op MijnETZ.
Belangrijke Overwegingen en Richtlijnen
De informatie in deze gids is gebaseerd op richtlijnen en consensus-based studies op het gebied van fertiliteitspreservatie. De ontwikkelingen op dit gebied gaan snel, wat leidt tot voortdurende updates van bestaande richtlijnen en de integratie van nieuwe methoden.
Historische Context en Ontwikkelingen
Richtlijnen met betrekking tot cryopreservatie van ovariumweefsel en het behoud van ovariële functie na kankerbehandeling zijn de basis geweest voor huidige praktijken. De snelle ontwikkelingen hebben geleid tot een breder scala aan opties voor fertiliteitspreservatie.
Doel en Doelgroep van Richtlijnen
De informatie is bedoeld voor zorgverleners die betrokken zijn bij de zorg voor kankerpatiënten en fertiliteitsbehoud. Een aangepaste uitgave is beschikbaar voor patiënten. De richtlijnen richten zich voornamelijk op volwassen vrouwen en de indicatie kanker, hoewel benigne en sociale indicaties niet worden uitgesloten.
Methodologie en Implementatie
De ontwikkeling van richtlijnen volgt evidence-based en consensus-based methoden. Implementatie in de praktijk wordt bevorderd door brede bekendmaking en gerichte interventies. IKNL (Integraal Kankercentrum Nederland) speelt een centrale rol in het onderhoud, beheer en de implementatie van deze richtlijnen.